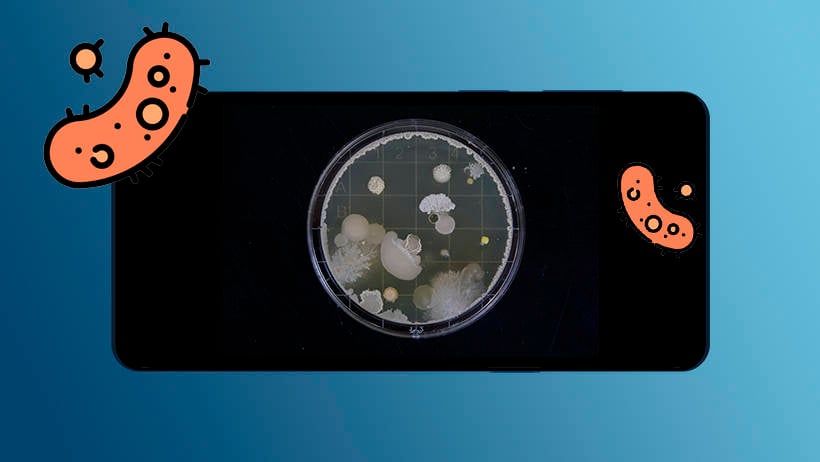
bacterias móviles rayos ultravioleta

Dicen que tendremos que aprender a convivir con el coronavirus y aunque esto aún no lo sabemos con seguridad, si sabemos que al menos la tecnología ya trabaja en métodos para desinfectar nuestro móvil y algunos gadgets con rayos ultravioleta. Desde hace años se lleva hablando de las propiedades de esta tecnología frente a los virus pero hasta ahora no había demasiados estudios.
Con la preocupación por el coronavirus todo parece haberse acelerado y se han comenzado a popularizar algunos dispositivos que hace años pasaban desapercibidos. Hoy conoceremos porque deberíamos tener que limpiar con especial hincapié nuestro móvil y además, el funcionamiento de los desinfectantes basados en rayos ultravioleta.
Limpiarse las manos y también el móvil
Durante el tiempo que llevamos bajo el estado de alarma se ha hablado mucho de la importancia de lavarnos las manos, pero no debemos olvidarnos de otras aspectos como por ejemplo la ropa, zapatillas y por supuesto los móviles o gadgets.
Antes de pasar a conocer como funciona la tecnología ultravioleta que desinfecta los móviles, debemos saber por qué debemos preocuparnos por los gérmenes que habitan en los móviles.
El móvil tiene hasta 10 veces más bacterias que un baño
Esta afirmación está demostrada por expertos en microorganismos que han podido comprobar como nuestros móviles y sobre todo las pantallas son capaces de acaparar una gran cantidad de gérmenes. A lo largo del día podemos desbloquear el móvil más de 50 veces y a esto debemos sumarle el tiempo que pasamos deslizando el dedo por la pantalla.

También te puede interesar: "Dispositivos para desinfectar nuestra casa de virus"
Estos dispositivos nos acompañan a todos lados, desde el cuarto de baño hasta la cocina o a la hora de hacer deporte. Nos preocupamos por la limpieza de todo, pero de estos dispositivos nos olvidamos fácilmente.
Los rayos ultravioleta son el mejor método de limpieza
Varios estudios realizados han demostrado que el mejor método de eliminar las bacterias es la luz ultravioleta. Con este tipo de luz se ha conseguido neutralizar incluso a las bacterias que éramos incapaces de eliminar con antibióticos.

Este hallazgo supuso un antes y un después en la lucha por frenar enfermedades tan graves como el coronavirus. Sin embargo hasta ahora no existían dispositivos que pudieran ofrecernos una solución tan sencilla y eficaz.
Cómo funciona el dispositivo que elimina bacterias
El gadgets que ha llamado nuestra atención se trata de una pequeña caja portátil que podemos usar de forma inalámbrica con su batería o bien enchufado. Únicamente tenemos que abrirlos y colocar nuestro móvil dentro para después cerrarlo y pulsar sobre le botón de encendido.
Funciona igual que lo puede hacer una cabina de rayos uva. Cuando la cerramos y los rayos comienzan a incidir sobre el móvil las bacterias comienzan a desintegrarse y quedar por lo tanto totalmente eliminadas.

Su eficiencia se sitúa en el 99%, lo que quiere decir que será prácticamente imposible que algunas bacterias o gérmenes quedan aún en nuestro móvil una vez haya terminado el proceso.
Otros gadgets o accesorios que se pueden desinfectar
El día que este producto llegue al mercado y podamos comenzar a comprarlo fácilmente, podremos utilizar no solo con nuestro móvil, sino también con accesorios como pulseras o joyas. Los gadgets también puedes pasar por los rayos ultravioleta para quedar libres de virus.
Hasta entonces, utiliza los desinfectantes clásicos
Mientras que esta tecnología avanza y evolución para llegar a nuestra casa, podemos seguir limpiando nuestro móvil y accesorios de una manera eficaz aunque algo más lenta. Con una pequeña toallita húmeda podemos pasarla por la pantalla del móvil y la parte trasera con cuidado de no utilizarla en los conectores le móvil.

Después lo secaremos y tendremos nuestro móvil limpio durante algunos días más. Depende también de nuestro uso la cantidad de bacterias que pueda adquirir por lo que no podemos recomendar un número de días para volver a repetir el proceso.
En MÁSMÓVIL queremos que las bacterias de tu móvil desaparezcan. Por eso te enseñamos como trabaja la tecnología para hacerlo posible con rayos ultravioleta. Si quieres información sobre nuestras ofertas, llámanos gratuitamente al 900 696 301 o consulta nuestra web.